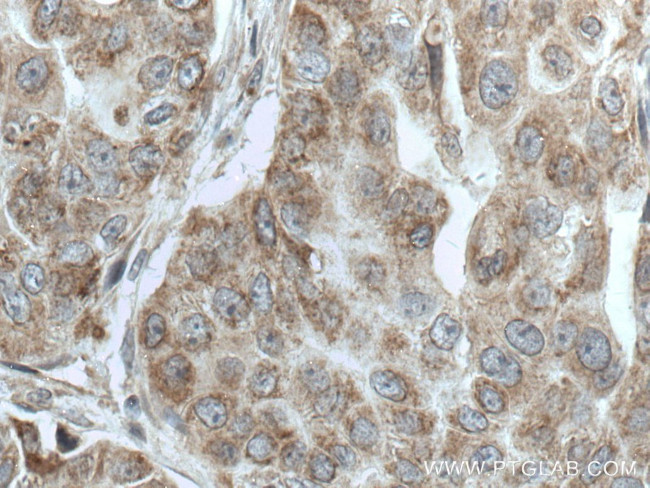
TTC19 Antibody in Immunohistochemistry (Paraffin) (IHC (P))

Search
Proteintech
TTC19 Polyclonal Antibody
{{$productOrderCtrl.translations['antibody.pdp.commerceCard.promotion.promotions']}}
{{$productOrderCtrl.translations['antibody.pdp.commerceCard.promotion.viewpromo']}}
{{$productOrderCtrl.translations['antibody.pdp.commerceCard.promotion.promocode']}}: {{promo.promoCode}} {{promo.promoTitle}} {{promo.promoDescription}}. {{$productOrderCtrl.translations['antibody.pdp.commerceCard.promotion.learnmore']}}
产品信息
20875-1-AP
种属反应
宿主/亚型
分类
类型
抗原
偶联物
形式
浓度
规格
纯化类型
保存液
内含物
保存条件
运输条件
产品详细信息
Immunogen sequence: EVQVPPSRV APHGRGPGLL PLLAALAWFS RPAAAEEEEQ QGADGAAAED GADEAEAEII QLLKRAKLSI MKDEPEEAEL ILHDALRLAY QTDNKKAITY TYDLMANLAF IRGQLENAEQ LFKATMSYLL GGGMKQEDNA IIEISLKLAS IYAAQNRQEF AVAGYEFCIS TLEEKIEREK ELAEDIMSVE EKANTHLLLG MCLDACARYL LFSKQPSQAQ RMYEKALQIS EEIQGERHPQ TIVLMSDLAT TLDAQGRFDE AYIYMQRASD LARQINHPEL HMVLSNLAAV LMHRERYTQA KEIYQEALKQ AKLKKDEISV QHIREELAEL SKKSRPLTNS VKL (41-383 aa encoded by BC011698)
靶标信息
This gene encodes a protein of unknown function. Alternatively spliced transcript variants have been identified, but their biological validity has not been determined.
仅用于科研。不用于诊断过程。未经明确授权不得转售。
生物信息学
蛋白别名: Tetratricopeptide repeat protein 19, mitochondrial; TPR repeat protein 19; unnamed protein product
基因别名: 2010204O13Rik; 2810460C24Rik; AI505442; MC3DN2; TTC19
UniProt ID: (Human) Q6DKK2, (Mouse) Q8CC21
Entrez Gene ID: (Human) 54902, (Mouse) 72795